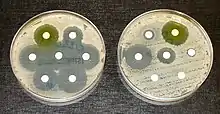

Siouxsie Wiles
Susanna Wiles, conocida como Siouxsie Wiles es una microbióloga y comunicadora científica británica radicada en Nueva Zelanda. Sus áreas de especialización son las enfermedades infecciosas y la bioluminiscencia. Es la directora del laboratorio de superbacterias bioluminiscentes de la Universidad de Auckland, en el que se utiliza la bioluminiscencia para mejorar la comprensión de las infecciones microbianas como la intoxicación alimentaria, la tuberculosis y las superbacterias hospitalarias.
Siouxsie Wiles | ||
---|---|---|
![]() | ||
Información personal | ||
Nacimiento |
Siglo XX Reino Unido | |
Nacionalidad | Neozelandesa | |
Familia | ||
Cónyuge | Steven D. Galbraith | |
Educación | ||
Educada en | Universidad de Edimburgo | |
Información profesional | ||
Ocupación | Divulgadora científica y microbióloga | |
Área | Microbiología | |
Empleador | ||
También es una comunicadora científica activa que aparece regularmente en los medios de comunicación de Nueva Zelanda y crea conciencia sobre las altas tasas de enfermedades infecciosas en Nueva Zelanda, así como el problema de la resistencia a los antibióticos.
Educación

Wiles nació en el Reino Unido, creció en el Reino Unido y Sudáfrica y fue criada por padres izquierdistas conscientes de la salud. Su madre es trabajadora social jubilada y su padre es propiestario de un negocio.[1]
El ébola fue el microbio que inició el interés de Wiles por la microbiología cuando era adolescente. Durante su charla TEDxChristchurch en 2015, dijo:[2]
Este es el microbio que me enganchó a la microbiología en primer lugar, porque es a la vez sorprendente y totalmente aterrador. Era una adolescente cuando leí por primera vez sobre el Ébola y todo lo que podía pensar era: ¿Cómo puede esto convertir el cuerpo humano en una fábrica de producción de virus?
El libro The Hot Zone de Richard Preston, que se centra en el ébola, fue lo que hizo que Wiles dedicara su educación en la microbiología médica.[3]
Wiles estudió en la Universidad de Edimburgo y se graduó en 1997 con un BSc (Hons) en Microbiología Médica. Mientras era estudiante, recibió una beca Nuffield y trabajó en la Facultad de Ciencias Biológicas de la universidad.[3] Completó su doctorado en el Centro de Ecología e Hidrología en Oxford, anteriormente conocido como Instituto de Virología y Microbiología Ambiental.[4][5]
Durante su doctorado, utilizó por primera vez la bioluminiscencia para crear biosensores para controlar la salud de los microbios beneficiosos para el medioambiente.[6]
Vida profesional
Después de completar su doctorado, Wiles se trasladó al Imperial College London para un puesto de investigación posdoctoral sobre tuberculosis. En 2007 se convirtió en profesora en el Departamento de Enfermedades Infecciosas e Inmunidad del Imperial College London,[7] y en 2009 recibió una beca Sir Charles Hercus del Consejo de Investigación en Salud de Nueva Zelanda y se trasladó a la Universidad de Auckland.[5] Es la directora del laboratorio de superbacterias bioluminiscentes de la universidad.[1][3]
En 2013 ganó el Premio del Primer Ministro de Comunicación Científica en Medios, que incluye un premio en metálico de NZ$ 100 000.[1][4]
Fundó la empresa Brightenz que vende kits con los que se puede crear arte bioluminiscente en casa.
En 2018, Wiles se convirtió en embajadora científica de House of Science, una empresa sin fines de lucro para aumentar la alfabetización científica en las comunidades locales.[8] También fue reelegida consejera general de la Royal Society Te Apārangi en 2018.[9] Dos años más tarde estaba en la lista de las 100 mujeres de la BBC que fue anunciada el 23 de noviembre de 2020.[10]
Wiles también está trabajando para encontrar nuevos antibióticos mediante la detección de 10 000 hongos de Nueva Zelanda para un posible uso médico.[11]
Laboratorio de superbacterias bioluminiscentes
Wiles dirige el laboratorio de superbacterias bioluminiscentes de la Universidad de Auckland, que se centra en cómo las bacterias brillantes pueden mejorar la comprensión de las infecciones microbianas como la intoxicación alimentaria, la tuberculosis y las superbacterias hospitalarias.[4]
La bioluminiscencia se utiliza para acelerar el proceso de desarrollo de nuevos antibióticos utilizando la luz emitida por las bacterias, porque solo las bacterias vivas emiten luz.[6] Acerca de su trabajo, Wiles dice: "Mi carrera se ha basado en hacer que las bacterias desagradables sean bioluminiscentes y usarlas para todo tipo de cosas, incluida la búsqueda de nuevos medicamentos".[12] Nueva Zelanda tiene algunas de las tasas más altas de enfermedades infecciosas entre los países desarrollados. En todo el mundo, 700 000 personas mueren cada año por enfermedades resistentes a los medicamentos.[13]
Comunicación científica
A Wiles le apasiona desmitificar la ciencia para el público en general. Es una bloguera activa en Sciblogs.co.nz, una generadora de podcasts en línea, una comentarista en Radio New Zealand y aparece en programas de televisión para discutir historias científicas en las noticias.[3] Fue una de los ocho científicos que encabezaron el "Gran Proyecto Científico de Nueva Zelanda", el programa de participación pública del gobierno de Nueva Zelanda que condujo a los Desafíos Científicos Nacionales en 2012.[4][7][6]
Comisionó, coescribió y apareció con su hija en el programa de ciencia infantil en línea de TVNZ Siouxsie & Eve Investigate.
Desde 2010 hasta 2016, Wiles fue coanfitrona de Completely Unnecessary Skeptical Podcast, que se centró en el escepticismo en Nueva Zelanda.[14]
También ha utilizado el arte y el cine para comunicar ideas científicas: en 2011 colaboró con el artista gráfico australiano Luke Harris para producir una serie de películas animadas con criaturas bioluminiscentes y sus usos en la ciencia. Las animaciones sobre el uso de luciérnagas por parte de la NASA para la búsqueda de vida extraterrestre fueron seleccionadas para su inclusión en el 6 ° Festival de Cine Imagine Science en Nueva York en 2013, y en el Festival de Cine Científico 2014 del Instituto Goethe. Wiles colaboró con la artista Rebecca Klee en una instalación en el Auckland Art in the Dark Festival en 2013, que contó con el calamar bobtail hawaiano y Aliivibrio fischeri.[1][3][4] Wiles piensa que la educación científica relevante debería comenzar en la escuela primaria, para aumentar la alfabetización científica y el interés en el campo en general.[8]

Sus proyectos de comunicación científica de 2015 incluyen la exposición Biolumination II.[15]
Participa activamente en el movimiento escéptico, ya que recibió el premio Escéptico del Año de los Escépticos de Nueva Zelanda en 2016 y asistió a varias Conferencias de Escépticos de Nueva Zelanda. También se ha pronunciado en contra de los antivacunas y otros problemas relacionados con la salud pública.[16][17]
En 2018 Wiles fue nombrada finalista de los premios Neozelandés del Año por su trabajo sobre superbacterias resistentes a los antibióticos y enfermedades infecciosas.[18]
Wiles ha estado a la vanguardia de la comunicación científica en Nueva Zelanda durante la pandemia de COVID-19.[19] Con el dibujante Toby Morris Wiles crearon "Flatten the Curve", un cómic GIF animado, para The Spinoff para describir cómo las simples acciones ciudadanas podrían reducir enormemente el número de muertos.[20] El cómic se volvió viral y se vio en todo el mundo (incluso en Wikipedia). Llamado "el cuadro que define el coronavirus", se basó en gráficos anteriores de los Centros para el Control y la Prevención de Enfermedades, Rosamund Pearce de The Economist y el profesor Drew Harris, de la Universidad Thomas Jefferson.[21][22]
En 2020 Wiles fue el tema de un corto documental titulado "Siouxsie and the Virus".[23]
Libros y publicaciones
Antibiotic Resistance
El libro Resistencia a los antibióticos: ¿el fin de la medicina moderna? se publicó en 2017 y examinó el creciente problema mundial de la resistencia a los antibióticos.[7][24] Al comentar sobre el libro, el profesor Kurt Krause, experto en enfermedades infecciosas de la Universidad de Otago, lo describió como "un claro llamado a la acción para los neozelandeses sobre uno de los problemas más críticos que enfrentamos".[24] Sarah-Jane O'Connor del Science Media Center escribe que el libro "[…] Antibiotic Resistance proporcionará un excelente tutorial para aquellos que saben que hay un motivo de preocupación pero necesitan algunos antecedentes adicionales para entender por qué".[25]
Vida personal
Wiles está casada con Steven Galbraith, profesor de matemáticas en la Universidad de Auckland.[26] Tienen una hija llamada Eva. Conoció a su esposo, un neozelandés, en Londres y dejó su puesto en el Imperial College London para mudarse a Nueva Zelanda en 2009.[1][3]
Es una fanática de LEGO y le gusta jugar con mientras critica lo que describe como el prejuicio de género en las minifiguras de Lego.[27] Se ha teñido el cabello desde que era adolescente y se la conoce como la "dama científica de cabello rosado".[5]
En una publicación de blog de 2013, Wiles dice que el nombre "Siouxsie" proviene de la cantante Siouxsie Sioux.[28]
Premios y reconocimientos
- Premio The Tree Rs del Centro Nacional del Reino Unido para el Reemplazo, Refinamiento y Reducción de Animales en la Investigación (NC3R) en 2005[5][7]
- Premio The Tree Rs del Comité Asesor Nacional de Ética Animal de Nueva Zelanda, 2011[5]
- Premio de Comunicación Científica de la Asociación de Científicos de Nueva Zelanda (ahora conocido como Medalla Cranwell ), 2012[5]
- Premio del Primer Ministro de Comunicación Científica en Medios, 2013[5][29]
- Medalla Callaghan de la Real Sociedad de Nueva Zelanda, 2013[5][29]
- Premio Blake Leader de Sir Peter Blake Trust, 2016[30]
- Premio al escéptico del año de los escépticos de Nueva Zelanda, 2016[17]
- Nombrada miembro de la Orden del Mérito de Nueva Zelanda, por sus servicios a la microbiología y la comunicación científica, en los honores de Año Nuevo de 2019[5][7]
- Ganadora Suprema, Premio Mujeres de Influencia de Nueva Zelanda, 2020[31]
Referencias
- Laxon, Andrew (23 de noviembre de 2013). «Michele Hewitson interview: Siouxsie Wiles». NZ Herald (en inglés). Consultado el 6 de febrero de 2021.
- «How Glowing Bacteria Can Save The World | Siouxsie Wiles | TEDxChristchurch». TEDx Talks (en inglés). 23 de noviembre de 2013.
- «Siouxsie Wiles». The University of Edinburgh (en inglés). Consultado el 6 de febrero de 2021.
- «The Prime Minister’s Science Media Communication Prize 2013». The Prime Minister’s Science Prizes (en inglés británico). 2013. Consultado el 6 de febrero de 2021.
- «Associate Professor Siouxsie Wiles». unidirectory.auckland.ac.nz (en inglés). Consultado el 6 de febrero de 2021.
- «Siouxsie Wiles». Royal Society Te Apārangi (en inglés). Consultado el 6 de febrero de 2021.
- «New Year Honours 2019 - Citations for Members of the New Zealand Order of Merit». New Zeland Government (en inglés). Department of the Prime Minister and Cabinet. 2018. Consultado el 6 de febrero de 2021.
- «Associate Professor Siouxsie Wiles announced as House of Science ambassador». Royal Society Te Apārangi (en inglés). 23 de julio de 2018. Consultado el 1 de marzo de 2021.
- «2018 Council Election - Results». Royal Society Te Apārangi (en inglés). 25 de mayo de 2018. Consultado el 1 de marzo de 2021.
- «BBC 100 Women 2020: Who is on the list this year?». BBC News (en inglés británico). 23 de noviembre de 2020. Consultado el 1 de marzo de 2021.
- Mulligan, Jesse (11 de abril de 2017). «Siouxsie Wiles on the end of antibiotics». RNZ (en inglés). Consultado el 1 de marzo de 2021.
- Park, Shuin (6 de septiembre de 2018). «Putting the Spotlight on Artists Who Glow». Signal to Noise (en inglés). Consultado el 1 de marzo de 2021.
- Morton, Jamie (7 de mayo de 2017). «Could superbug 'Kryptonite' be in NZ forests?». NZ Herald (en en-NZ). Consultado el 1 de marzo de 2021.
- «About The CUSP». The CUSP (en inglés). 17 de diciembre de 2021. Archivado desde el original el 20 de octubre de 2016. Consultado el 1 de marzo de 2021.
- Wiles, Siouxsie (23 de marzo de 2015). «thinkScience at the Auckland Arts Festival – Biolumination II». Sciblogs (en inglés estadounidense). Consultado el 1 de marzo de 2021.
- Nicaise, Alexander (10 de febrero de 2020). «NZ Skeptic Conference - Christchurch - 2019». Skeptical Inquirer (en inglés estadounidense). Consultado el 1 de marzo de 2021.
- «Denis Dutton Award for New Zealand Skeptic of the Year». NZ Skeptics (en inglés). Consultado el 1 de marzo de 2021.
- «New Zealander of the Year Finalists Announced». nzawards.org.nz (en inglés). 30 de enero de 2018. Consultado el 1 de marzo de 2021.
- Macdonald, Nikki (20 de marzo de 2020). «Scientist Siouxsie Wiles has dropped everything to tell Kiwis about coronavirus». Stuff (en inglés). Consultado el 1 de marzo de 2021.
- Manhire, Toby (14 de marzo de 2020). «Covid-19: All arrivals to NZ must self-isolate for 14 days. Here's what you need to know». The Spinoff (en inglés). Consultado el 1 de marzo de 2021. «Jacinda Ardern with a print-out of the Spinoff 'Flatten the Curve' visual by Siouxsie Wiles and Toby Morris. »
- Chow, Denise (11 de marzo de 2020). «Don't think it matters if you catch coronavirus? Look at this chart.». NBC News (en inglés). Consultado el 1 de marzo de 2021.
- Wilson, Mark (13 de marzo de 2020). «The story behind ‘flatten the curve,’ the defining chart of the coronavirus». Fast Company (en inglés estadounidense). Consultado el 1 de marzo de 2021.
- «Covid-19 scientist Siouxsie Wiles reveals appalling social media abuse». New Zeland Herald (en inglés). 3 de julio de 2020. ISSN 1170-0777. Consultado el 1 de marzo de 2021.
- «Antibiotic Resistance». www.bwb.co.nz (en inglés). Consultado el 1 de marzo de 2021.
- O'Connor, Sarah-Jane (21 de abril de 2017). «Book review: Antibiotic Resistance – the end of modern medicine?». Sciblogs (en inglés). Consultado el 1 de marzo de 2021.
- «Steven Galbraith». University of Auckland (en inglés). Consultado el 1 de marzo de 2021.
- Wiles, Siouxsie (19 de mayo de 2015). «Building blocks of bias: Lego and gender». YouTube (en inglés). TEDxAuckland. Consultado el 1 de marzo de 2021.
- Wiles, Siouxsie (4 de febrero de 2013). «So just how did I get my name?». Sciblogs (en inglés). Consultado el 1 de marzo de 2021.
- «2018 New Zealander of the Year finalist - Dr Siouxsie Wiles». Royal Society Te Apārangi (en inglés). 23 de febrero de 2018. Consultado el 1 de marzo de 2021.
- Barraclough, Breanna (1 de julio de 2016). «Sir Peter Blake Trust honours leaders at black-tie awards». Newshub (en inglés). Consultado el 1 de marzo de 2021.
- Nadkarni, Anuja (17 de noviembre de 2020). «Dr Siouxsie Wiles supreme winner at Stuff-Westpac 2020 Women of Influence Awards». Stuff (en inglés). Consultado el 1 de marzo de 2021.
Enlaces externos
- Sitio web personal
- Perfil de la Universidad de Auckland
- Pensamientos infecciosos sobre Sciblogs.co.nz
- Siouxsie Wiles en Blogspot
- Sitio web de Bioluminiscent Superbugs Lab